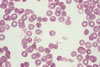

| Brucella |
|---|

Brucella |

Brucella |
| Brusella hastal��� bakterisi. Bruselloz da dahil olmak �zere �e�itli hastal�klara yol a�an bakterinin ad�d�r. |
| Brucella |
|---|

Brucella |
Brucella |
| Brusella hastal��� bakterisi. Bruselloz da dahil olmak �zere �e�itli hastal�klara yol a�an bakterinin ad�d�r. |